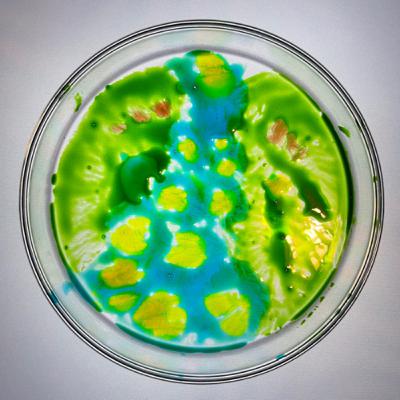

#11 香有さんのやわらかい壁。「うきうき鳳凰」
Update: 2022-05-27
Description
今回のセッション相手は、香有さんです。
香有さんがわたしへ届けてくれた石のはなしや、わたしのishimedeliumでの石拾いについて、香有さんがつくりたい禅センター、自分の人生の舵をきることについてなど、いっしょにおはなししました。
今回の「やわらかい壁。」も、水彩で描いてみました。
タイトルは、
「うきうき鳳凰」
32分ごろ 描きはじめ。
53分ごろ やわ壁、完成。
香有さんの話を聴きながら、じっくりゆっくり描きました。
だから線が細かったり、太かったり。いろんな要素が詰まったやわ壁になりました。
👇Instagram
https://instagram.com/yawarakai_kabe
香有さんがわたしへ届けてくれた石のはなしや、わたしのishimedeliumでの石拾いについて、香有さんがつくりたい禅センター、自分の人生の舵をきることについてなど、いっしょにおはなししました。
今回の「やわらかい壁。」も、水彩で描いてみました。
タイトルは、
「うきうき鳳凰」
32分ごろ 描きはじめ。
53分ごろ やわ壁、完成。
香有さんの話を聴きながら、じっくりゆっくり描きました。
だから線が細かったり、太かったり。いろんな要素が詰まったやわ壁になりました。
https://instagram.com/yawarakai_kabe
Comments
In Channel